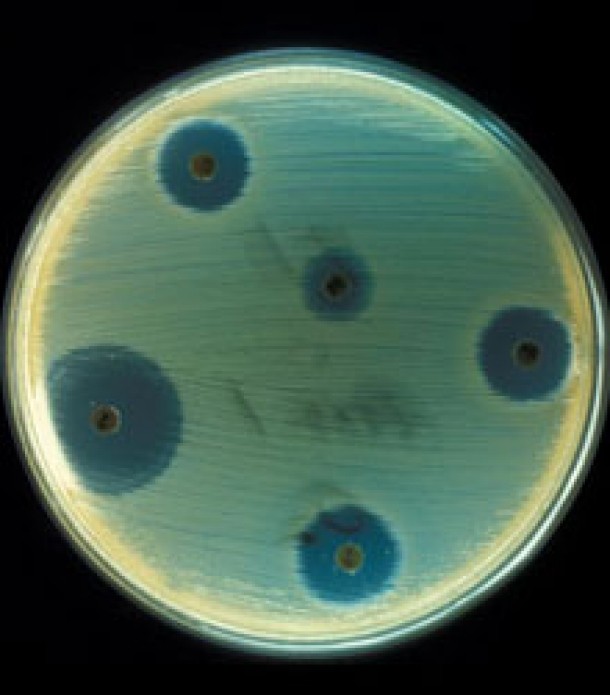

Bacteria, care produce enzima de tip "New Delhi metalo-beta-lactamaza" (NDM-1), a fost identificata prima data in 2009, de profesorul Timothy Walsh, la un pacient suedez care fusese tratat in India.
Potrivit unui studiu publicat in revista britanica The Lancet Infectious Diseases, cercetatorii au izolat 37 de pacienti in Marea Britanie, multi dintre care calatorisera in India si Pakistan pentru operatii estetice. "NDM-1 are potentialul de a se transmite la nivel mondial; este necesara o supraveghere coordonata", avertizeaza autorii studiului, explicand ca numerosi pacienti europeni si americani apeleaza la servicii de chirurgie estetica in India.
NDM-1 rezista practic la toate tipurile de antibiotice, inclusiv la carbapenem, folosit de obicei in cazuri de infectii grave.

Hreanul, un deliciu care lupta impotriva cancerului
Hreanul, un deliciu care lupta impotriva cancerului
 Animalele de companie, vitale evolutiei umane
Animalele de companie, vitale evolutiei umane













































